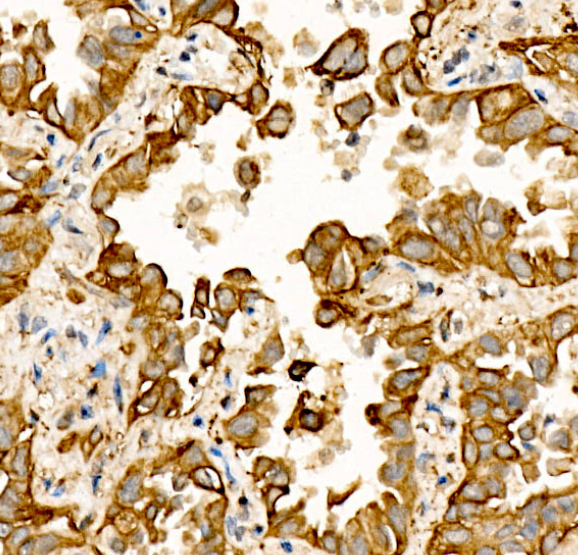
3

| 经过测试的应用 | |
| WB | WB-1/500 - 1/1000 |
| IHC-P | IHC-P-1/100 - 1/500 |
| IF/ICC | IF/ICC1/50-1/200 |
| ELISA | Recommended starting concentration is 1 μg/mL. Please optimize the concentration based on your specific assay requirements. |
| 反应物种 | Human, Mouse, Rat |
| 同种型 | IgG |
| 偶联物 | Unconjugated |
| 宿主 | Rabbit IgG1 |
| 基因名 | WNT5A |
| 分子量 | 45 kDa |
| 形式 | Liquid |
| 存储缓冲液 | Buffer: PBS containing 50% glycerol, preserved with proclin300 or sodium azide (as specified on the Certificate of Analysis), pH 7.3 |
| 储存 | Store at 4°C short term. Aliquot and store at -20°C long term. Avoid freeze/thaw cycles. |

Western blot analysis of various lysates using at 1:1000 dilution.
Secondary antibody: HRP-conjugated Goat anti-Rabbit IgG (H+L) at 1:10000 dilution

Immunohistochemistry analysis of paraffin-embedded Human thyroid cancer tissue using WNT5A Rabbit pAb at a dilution of 1:300 (40x lens)
Immunohistochemistry analysis of paraffin-embedded Human lung cancer tissue using WNT5A Rabbit pAb at a dilution of 1:300 (40x lens).

Immunohistochemistry analysis of paraffin-embedded Human placenta tissue using WNT5A Rabbit pAb at a dilution of 1:300 (40x lens).

Immunofluorescence analysis of PC-12 cells using WNT5A Rabbit pAb at dilution of 1:50 (40x lens). Secondary antibody: Cy3-conjugated Goat anti-Rabbit IgG (H+L) at 1:500 dilution
×